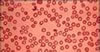

| Losemi |

Losemi |

Losemi |

Losemi |
| Kan kanseri,akyuvar kanseri.Akyuvarların anormal bir hızla büyümesiyle belirlenen bir kanser tipi. |
| Losemi |

Losemi |
Losemi |

Losemi |
| Kan kanseri,akyuvar kanseri.Akyuvarların anormal bir hızla büyümesiyle belirlenen bir kanser tipi. |